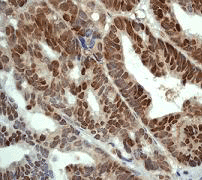

> Antigen, Antibodies, ELISA, Western Blot > Primary Antibody > Monoclonal Antibodies > Nrf2 Antibody Phospho (pS40)Brand |
Leading Biology | Catalog Number |
APR08835G |
Product Type |
Monoclonal Antibodies | Field of Research |
|
Product Overview |
We constantly strive to ensure we provide our customers with the best antibodies. As a result of this work we offer this antibody in purified format.
We are in the process of updating our datasheets. If you have any questions regarding this update, please feel free to contact our technical support team.
This product is a high quality Nrf2 antibody Phospho (pS40).
|
||
Molecular Weight |
67827 Da
|
||
Cellular Localization |
Antigen Cellular Localization:
Cytoplasm, cytosol. Nucleus. Note=Cytosolic under unstressed conditions, translocates into the nucleus upon induction by electrophilic agents
|
||
Host |
Rabbit
|
||
Species Reactivity |
Human
|
||
Target |
A synthetic peptide corresponding to residues near the serine 40 of human Nrf2 protein.
|
||
Clone |
EP1809Y
|
||
Symbol |
NRF2
|
||
GeneID |
|||
UniProt ID |
|||
Function |
Transcription activator that binds to antioxidant response (ARE) elements in the promoter regions of target genes. Important for the coordinated up-regulation of genes in response to oxidative stress. May be involved in the transcriptional activation of genes of the beta-globin cluster by mediating enhancer activity of hypersensitive site 2 of the beta-globin locus control region.
|
||
Summary |
Nuclear factor erythroid 2-related factor 2 (Nrf2) is a transcription factor which belongs to the Cap N Collar (CNC-bZIP) subfamily with an implication in adaptive responses to oxidative stress (1). Nrf2 is a basic leucine zipper transcription factor that can bind to a NF-E2/AP-1 repeat sequence in the promoter of the beta-globin gene and has two types of binding partners, a cytoplasmic repressor (Keap I) and multiple nuclear binding partners. During oxidative stress on a cell, Nrf2 is released from Keap I, possibly via PKC phosphorylation at serine 40, and translocates to the nucleus. In the nucleus, Nrf2 binds to antioxidant responsive element (ARE) and leads to transcriptional activation of downstream genes for GSTs, glutamate-cysteine ligase, HO-1, and thioredoxin (2). Nrf2 and its downstream proteins have shown to have important functions in protection against oxidative stress or chemical-induced cellular damage in liver and lung, prevention in cancer formation in GI tract, and promotion of the wound-healing process (3).
|
||
Form |
50 mM Tris-Glycine (pH 7.4), 0.15 M NaCl, 40% Glycerol, 0.01% sodium azide and 0.05% BSA. |
||
Storage & Stability |
Store at +4°C short term. For long-term storage, aliquot and store at -20°C or below. Stable for 12 months at -20°C. Avoid repeated freeze-thaw cycles.
|
||
Applications |
WB, IHC
|
||
Dilution |
WB~~1:1000~10000
IHC~~1:100~250
|
||
Synonyms |
Nuclear factor erythroid 2-related factor 2, NF-E2-related factor 2, NFE2-related factor 2, HEBP1, Nuclear factor, erythroid derived 2, like 2, NFE2L2, NRF2
|
||
Images |

A. Western blot analysis on A) untreated and B) AP treated HepG2 cell lysates using anti-Phospho-Nrf2 (pS40) RabMAb (Cat. APR08835G), 1:20,000 dilution.
B. Immunohistochemical analysis of paraffin-embedded human breast carcinoma using anti-NRF2 RabMAb (Cat. APR08835G) |
||
Specification |
|||
Quantity |
|
||
| Select | Brand | Catalog No. | Product Name | Pack Size | Type | Field of Research | Specification | Quantity | Price(USD) | |
| 1 | Leading Biology | APG02467G | CCK4 / PTK7 Antibody (clone 4F9) | 50 μl | Monoclonal Antibodies |
|
$495.00 | Add Ask | ||
| 2 | Leading Biology | AMM04683G | GALT Antibody (clone 4C11) | 50 μg | Monoclonal Antibodies |
|
$545.00 | Add Ask | ||
| 3 | Leading Biology | AMM01402G | Vimentin (Mesenchymal Cell Marker) Antibody - With BSA and Azide | 50 ug | Monoclonal Antibodies |
|
$395.00 | Add Ask | ||
| 4 | Leading Biology | APR08280G | LTA4H / LTA4 Antibody (clone 9G8) | 50 μl | Monoclonal Antibodies |
|
$495.00 | Add Ask | ||
| 5 | Leading Biology | AMM00172G | CD1a / HTA1 (Mature Langerhans Cells Marker) Antibody - With BSA and Azide | 50 ug | Monoclonal Antibodies |
|
$395.00 | Add Ask | ||
| 6 | Leading Biology | AMM05750G | CEBPA Antibody | 100 μl | Monoclonal Antibodies |
|
$545.00 | Add Ask |
 Leading Biology Inc.
2600 Hilltop DR, Building G, B Suite C138
Richmond, CA, 94806
Tel: 1-661-524(LBI)-0262
Email: info@leadingbiology.com
Leading Biology Inc.
2600 Hilltop DR, Building G, B Suite C138
Richmond, CA, 94806
Tel: 1-661-524(LBI)-0262
Email: info@leadingbiology.com
Complete this form and click send to ask us a question, request a quote or simply say hello.

You have 0 item in your cart

You have 0 item in your inquiry list
